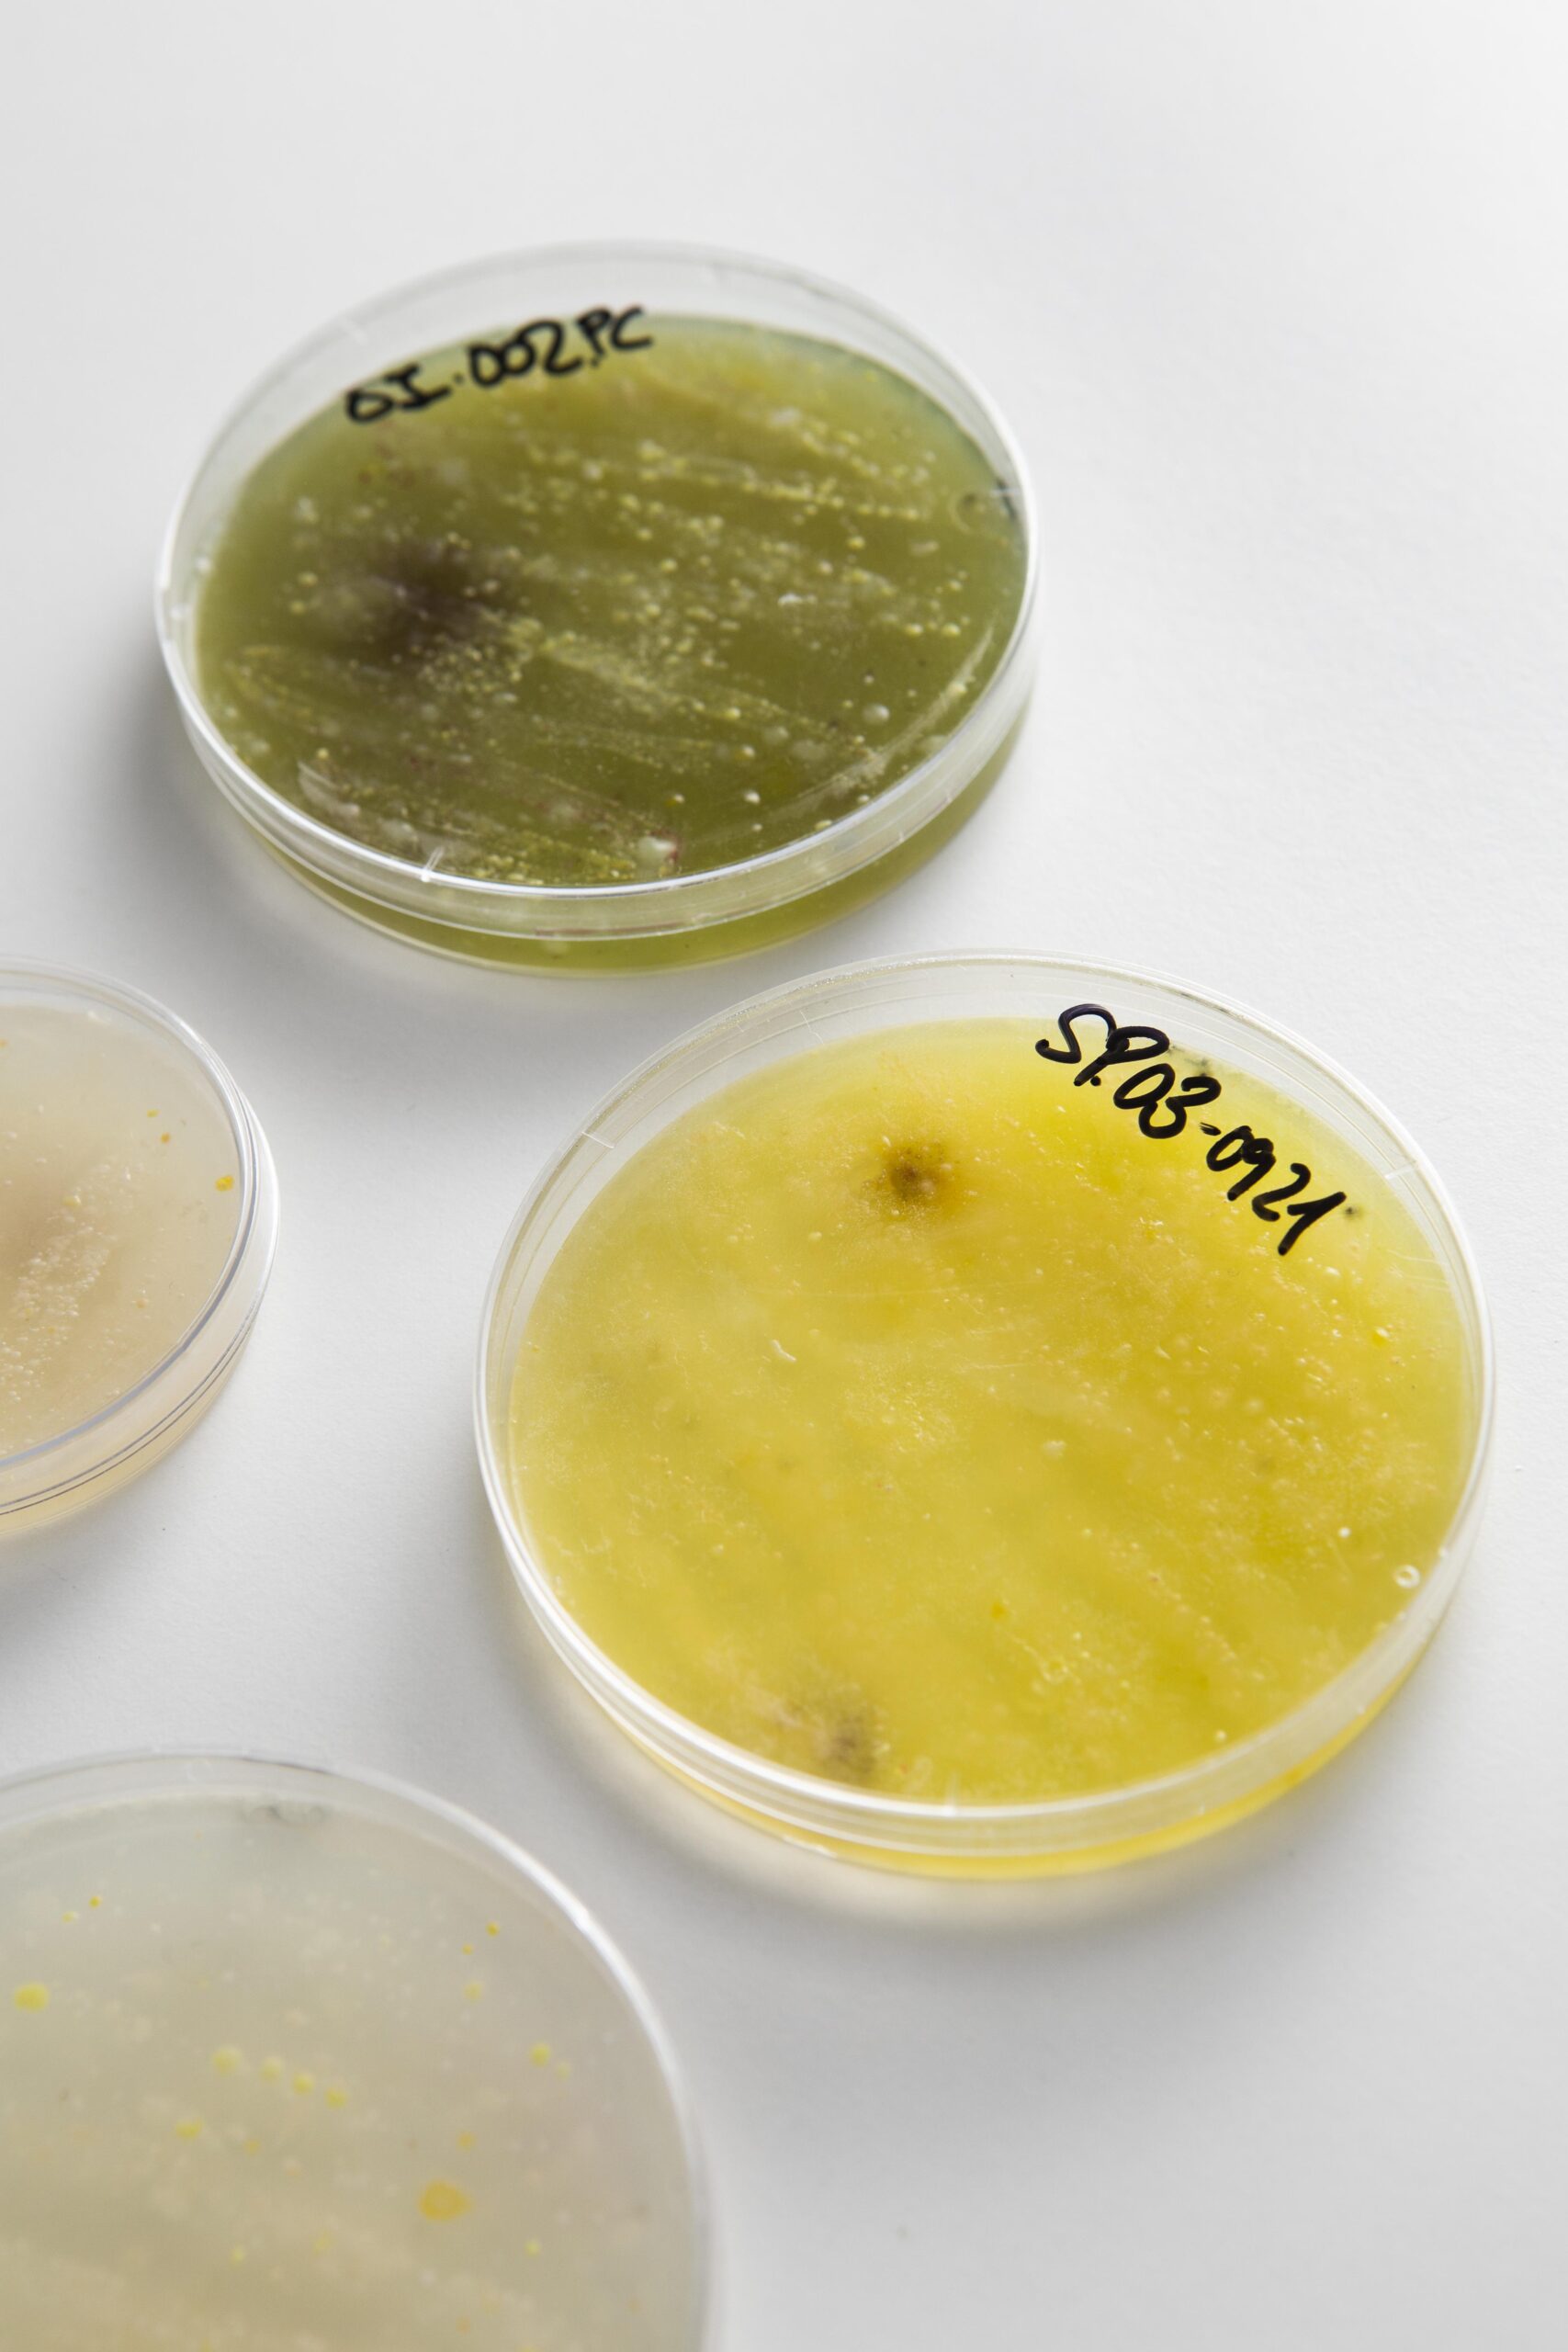

🧫 Microbiome Tests
Introduction
The human microbiome, consisting of trillions of microorganisms living in our gut, skin, and other tissues, plays a crucial role in health and disease. Microbiome testing allows us to analyze this complex ecosystem, providing insights into digestion, immunity, metabolism, and even mental health. Understanding the microbiome is becoming a key step in developing truly personalized healthcare solutions.

Clinical Applications
Microbiome tests are being applied in multiple fields of medicine and preventive healthcare:
Gastrointestinal Disorders: Identifying imbalances linked to irritable bowel syndrome (IBS), Crohn’s disease, and ulcerative colitis.
Metabolic Health: Detecting microbial patterns associated with obesity, diabetes, and metabolic syndrome.
Immunology: Understanding the gut-immune connection to manage autoimmune diseases and allergies.
Mental Health: Exploring the gut-brain axis in conditions such as depression, anxiety, and neurodegenerative diseases.
Nutrition & Lifestyle: Creating personalized diet and probiotic recommendations to improve health outcomes.
Advantages
Microbiome tests provide unique benefits compared to traditional diagnostics:
Non-invasive and easy-to-collect samples (e.g., stool, saliva, skin swabs).
Personalized insights into health and disease risks.
Early detection of imbalances before symptoms develop.
Tailored lifestyle and dietary interventions.
Potential to guide treatment choices and improve outcomes.
Future Outlook
With advances in sequencing technologies and bioinformatics, microbiome testing will soon become a routine part of preventive healthcare. Combined with artificial intelligence, these tests will not only map microbial diversity but also predict disease risk, guide targeted therapies, and support the development of next-generation probiotics. The future of microbiome testing lies in making healthcare more predictive, preventive, and personalized.



